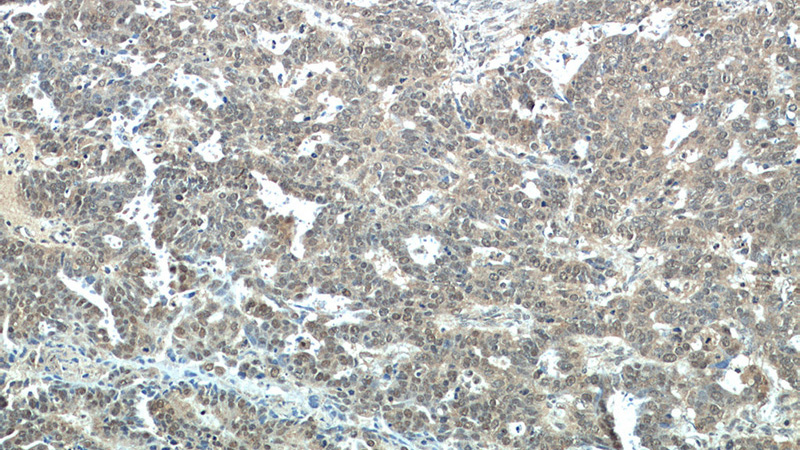
Immunohistochemical of paraffin-embedded human ovary tumor using Catalog No:112676(MLH1 antibody) at dilution of 1:50 (under 10x lens)

-
Product Name
MLH1 antibody
- Documents
-
Description
MLH1 Rabbit Polyclonal antibody. Positive IP detected in HeLa cells. Positive WB detected in HEK-293 cells, A431 cells, HeLa cells, human testis tissue, Jurkat cells. Positive IHC detected in human ovary tumor tissue. Observed molecular weight by Western-blot: 85 kDa
-
Tested applications
ELISA, WB, IHC, IP
-
Species reactivity
Human,Mouse,Rat; other species not tested.
-
Alternative names
COCA2 antibody; FCC2 antibody; hMLH1 antibody; HNPCC antibody; HNPCC2 antibody; MLH1 antibody; MutL protein homolog 1 antibody
-
Isotype
Rabbit IgG
-
Preparation
This antibody was obtained by immunization of MLH1 recombinant protein (Accession Number: NM_000249). Purification method: Antigen affinity purified.
-
Clonality
Polyclonal
-
Formulation
PBS with 0.1% sodium azide and 50% glycerol pH 7.3.
-
Storage instructions
Store at -20℃. DO NOT ALIQUOT
-
Applications
Recommended Dilution:
WB: 1:500-1:5000
IP: 1:200-1:2000
IHC: 1:20-1:200
-
Validations

HEK-293 cells were subjected to SDS PAGE followed by western blot with Catalog No:112676(MLH1 antibody) at dilution of 1:500
Immunohistochemical of paraffin-embedded human ovary tumor using Catalog No:112676(MLH1 antibody) at dilution of 1:50 (under 10x lens)

IP Result of anti-MLH1 (IP:Catalog No:112676, 3ug; Detection:Catalog No:112676 1:500) with HeLa cells lysate 3200ug.
-
Background
MLH1, also named as CocA2, belongs to the DNA mismatch repair mutL/hexB family. It heterodimerizes with PMS2 to form MutL alpha which is a component of the post-replicative DNA mismatch repair system (MMR). MutL alpha (MLH1-PMS2) interacts physically with the clamp loader subunits of DNA polymerase III, suggesting that it may play a role to recruit the DNA polymerase III to the site of the MMR. MLH1 also implicated in DNA damage signaling, a process which induces cell cycle arrest and can lead to apoptosis in case of major DNA damages. MLH1 heterodimerizes with MLH3 to form MutL gamma which plays a role in meiosis.(PMID: 16873062, PMID: 18206974) Defects in MLH1 are the cause of hereditary non-polyposis colorectal cancer type 2 (HNPCC2). Defects in MLH1 are a cause of mismatch repair cancer syndrome (MMRCS). Defects in MLH1 are a cause of Muir-Torre syndrome (MTS). Defects in MLH1 are a cause of susceptibility to endometrial cancer. This antibody is specific to MLH1.
-
References
- Jin P, Lu XJ, Sheng JQ. Estrogen stimulates the expression of mismatch repair gene hMLH1 in colonic epithelial cells. Cancer prevention research (Philadelphia, Pa.). 3(8):910-6. 2010.
- He YQ, Sheng JQ, Ling XL. Estradiol regulates miR-135b and mismatch repair gene expressions via estrogen receptor-β in colorectal cells. Experimental & molecular medicine. 44(12):723-32. 2012.
Related Products / Services
Please note: All products are "FOR RESEARCH USE ONLY AND ARE NOT INTENDED FOR DIAGNOSTIC OR THERAPEUTIC USE"
